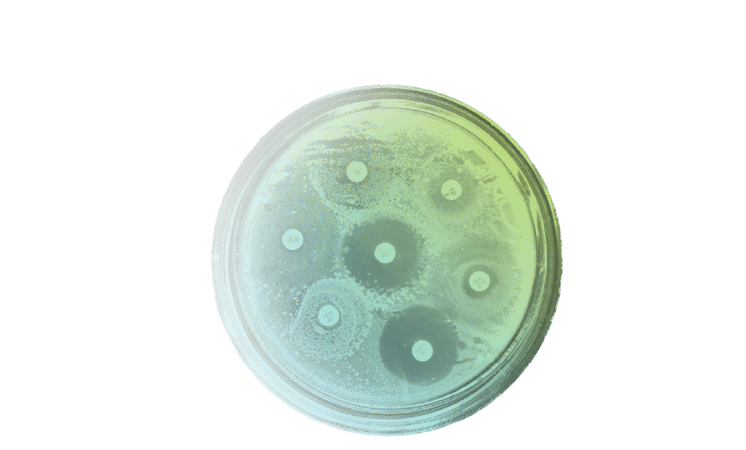

A growing Threat
The world is losing one of its most powerful tools in healthcare: antibiotics and other antimicrobial drugs.
The reason: the rapid rise of antimicrobial resistance, or AMR. This occurs when bacteria evolve and become resistant to existing medications. Infections caused by antimicrobial-resistant bacteria can affect anyone, of any age, in any country. AMR is now a leading global killer and a looming economic catastrophe.


Health Impact
4.78
Million
Annual global deaths associated with AMR
2.16
million
Annual AMR-associated deaths among adults 70 years or older
10
Million
Estimated annual AMR deaths in 2050
Economic Impact
$100
trillion
Potential cost of AMR to global economy by 2050
28
Million
People potentially pushed into extreme poverty due to AMR by 2050

A Menace to Modern Medicine
Antimicrobials are a cornerstone of modern medicine that have saved many millions of lives and alleviated untold suffering. But the rise of AMR imperils patients and jeopardizes clinicians’ ability to safely provide a wide range of care, from performing surgery and organ transplantations to treating cancer and delivering babies.

A Paucity of Investment and Innovation
Because new antimicrobials are used sparingly, companies struggle to recoup their investments. As a result, private investment into the field is low and several biotechs have gone bankrupt in recent years after successfully developing new antibiotics.
10-15
years
Average time needed to develop a new antibiotic
>$1
Billion
Average cost of developing a new antibiotic
<50
Antibacterial agents in clinical development that target WHO priority pathogens
A Catalyst for Innovation
2 to 4
Number of new antimicrobials the AMR Action Fund aims to help launch within the next decade
$1
Billion
Approximate amount we are investing in biotechnology companies developing new treatments for priority drug-resistant pathogens
In addition to investing, we advocate for solutions to overcome the scientific and commercial challenges of antimicrobial development
